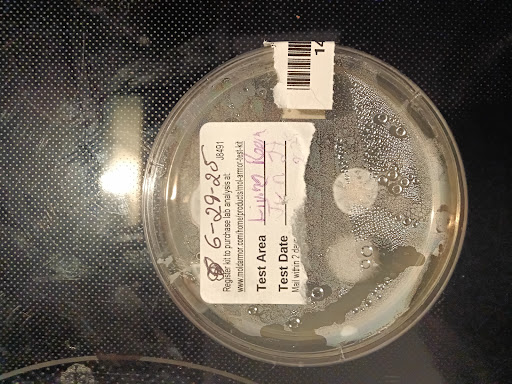

WaterWalk Extended Stay Charlotte - Arrowood things to do, attractions, restaurants, events info and trip planning

Basic Info
WaterWalk Extended Stay Charlotte - Arrowood
1525 W Arrowood Rd, Charlotte, NC 28217
3.0(116)
Ratings & Description
Info
attractions: Spirit of Liberty Worship Center, Black Out, restaurants: Stephie's Kitchen, Ruby Tuesday, Cafe South, Pasta Americana, MrBeast Burger, Sonic Drive-In, Wow Bao at Ruby Tuesday - Charlotte (NC), local businesses: No Filter Esthetics, Spectrum, Komfort Air Service Experts, Corporate Headquarters-- Bojangles' Restaurants, Inc.
 Learn more insights from Wanderboat AI.
Learn more insights from Wanderboat AI.Phone
(980) 249-3986
Website
wyndhamhotels.com
Plan your stay

Pet-friendly Hotels in Charlotte
Find a cozy hotel nearby and make it a full experience.

Affordable Hotels in Charlotte
Find a cozy hotel nearby and make it a full experience.

The Coolest Hotels You Haven't Heard Of (Yet)
Find a cozy hotel nearby and make it a full experience.

Trending Stays Worth the Hype in Charlotte
Find a cozy hotel nearby and make it a full experience.
Reviews
Live events

90’s Music Bingo @ Middle James Brewing - Pineville
Sat, Feb 28 • 6:00 PM
400 North Polk Street #B Pineville, NC 28134
View details

Cats they are just... Different
Sun, Mar 1 • 9:00 AM
929 E garrison Blvd. Suite 8 Gastonia, NC 28054
View details

Tap your inner artisan & craft your own bracelet
Wed, Feb 25 • 11:30 AM
Charlotte, North Carolina, 28205
View details
Nearby attractions of WaterWalk Extended Stay Charlotte - Arrowood
Spirit of Liberty Worship Center
Black Out

Spirit of Liberty Worship Center
5.0
(10)
Open until 12:00 AM
Click for details

Black Out
4.9
(51)
Closed
Click for details
Nearby restaurants of WaterWalk Extended Stay Charlotte - Arrowood
Stephie's Kitchen
Ruby Tuesday
Cafe South
Pasta Americana
MrBeast Burger
Sonic Drive-In
Wow Bao at Ruby Tuesday - Charlotte (NC)

Stephie's Kitchen
4.8
(133)
$
Click for details

Ruby Tuesday
3.8
(1.2K)
$
Open until 10:00 PM
Click for details

Cafe South
4.5
(1.4K)
$
Open until 3:00 PM
Click for details

Pasta Americana
2.5
(17)
$$
Open until 10:00 PM
Click for details
Nearby local services of WaterWalk Extended Stay Charlotte - Arrowood
No Filter Esthetics
Spectrum
Komfort Air Service Experts
Corporate Headquarters-- Bojangles' Restaurants, Inc.

No Filter Esthetics
5.0
(16)
Click for details

Spectrum
2.6
(154)
Click for details

Komfort Air Service Experts
4.8
(709)
Click for details

Corporate Headquarters-- Bojangles' Restaurants, Inc.
1.9
(52)
Click for details
The hit list

Plan your trip with Wanderboat
Welcome to Wanderboat AI, your AI search for local Eats and Fun, designed to help you explore your city and the world with ease.
Powered by Wanderboat AI trip planner.